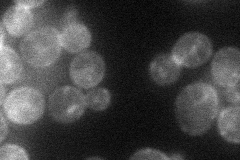
YPR122W

View description
Haploid specific endoprotease that performs one of two N-terminal cleavages during maturation of a-factor mating pheromone; required for axial budding pattern of haploid cells
Localization:
Intensity:
Fold change:
Significance:
-
C’ GFP library in SD

punctate62.17 -
N' NOP1pr-GFP in SD

bud neck45.6889 -
N' TEF2pr-mCherry in SD
ER,punctate26.8893 -
N' NATIVEpr-GFP in SD

below threshold21.4145 -
N' TEF2pr-VC and Cyto-VN in SD

below threshold26.7648 -
C’ GFP library in SD+DTT

punctate72.761.17No -
C’ GFP library in SD+H2O2

punctate69.911.12No -
C’ GFP library in Starvation Media

punctate66.481.06No -
C’ GFP library on the background of Pup2-DaMP

punctate -
C’ GFP library on the background of CCT mutant

punctate73.49731.1821No
